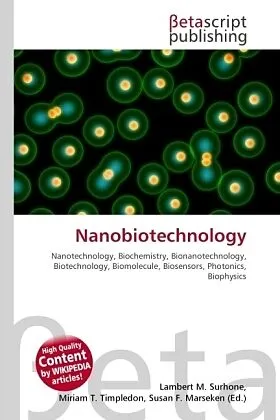

Beschreibung
High Quality Content by WIKIPEDIA articles! Nanobiotechnology is the branch of nanotechnology with biological and biochemical applications or uses. Nanobiotechnology often studies existing elements of nature in order to fabricate new devices. The term bionanot...